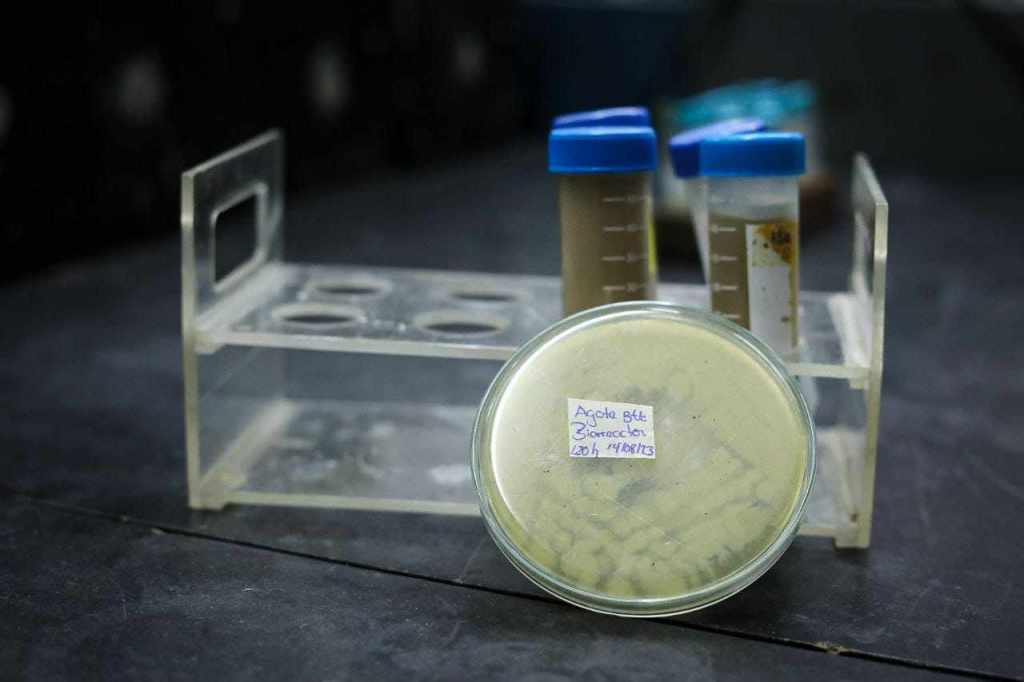

En los últimos años, en las costas de los estados Sucre, Monagas y Delta Amacuro, ha proliferado la presencia de la Hylesia Metabus, conocida popularmente como palometa peluda, un insecto que se caracteriza por expulsar al ambiente grandes cantidades de espículas o setas urticantes que pueden generar reacciones alérgicas y dermatitis.

Según el libro “Estudio multidisciplinario de la palometa peluda Hylesia metabus”, presentado por el Instituto Venezolano de Investigaciones Científicas (IVIC) en 2012, la incrustación de estás espículas en la piel de las personas “produce un prurito intenso y erupciones cutáneas que persisten por semanas”.
La invasión de estas palometas, al ser atraídas por el alumbrado público y residencial, pone en riesgo la salud de la población del oriente del país, principalmente. Conocer las causas del aumento poblacional de este lepidóptero y proponer un manejo biológico de la especie durante sus ciclos de vuelos es fundamental para su control.

El Gobierno Bolivariano, a través del Ministerio del Poder Popular para Ciencia y Tecnología (Mincyt), promueve estudios, proyectos e innovaciones científicas y tecnológicas, que involucran a universidades y centros de investigaciones, para encontrar solución al problema.
Expertos de la Universidad Central de Venezuela (UCV), Universidad Simón Bolívar (USB), Universidad de Oriente (UDO); Instituto Nacional de Salud Agrícola Integral (INSAI); junto a los ministerios para Salud y Ecosocialismo, apoyados por Fondo Nacional de Ciencia, Tecnología e Innovación (Fonacit), en el año 2005 se impulsa el proyecto Reto Hylesia Metabus, divididos en ocho subproyectos enfocados en genética, biodiversidad, feromonas, monitorización, bioquímica, inmunológica, educación, microbiología y participación ciudadana.
De esta área de la ciencia, que estudia los microorganismos, bacterias, hongos, protistas y parásitos, nace el primer bioinsecticida desarrollado, llamado Beauver.
Se trata de un biocontrolador formulado con esporas del hongo entomoptógeno Beauveria bassiana, comúnmente utilizado como insecticida biológico por su eficacia contra numerosas plagas en una amplia variedad de cultivos.
En el Laboratorio de Procesos Fermentativos del Instituto de Biología Experimental (IBE) de la UCV, avanzan en el desarrollo de cinco biocontroladores que prometen revolucionar la salud pública, enfocados en el control de plagas y enfermedades agrícolas.
“En el Laboratorio de Procesos Fermentativos del IBE hemos desarrollado procesos microbiológicos para producir bacterias y hongos que son utilizados para el control de plagas y enfermedades. Es un proyecto de investigación y desarrollo que se introdujo hace un año y medio, y su objetivo es el desarrollo de cinco agentes microbianos para el control de plagas. La idea era desarrollar los bioinsecticidas a partir de esos organismos, algunos están en colección, en el Centro Venezolano de Colecciones de Microorganismos, fueron puestos allí por nosotros mismos y nuestras investigaciones, otros fueron desarrollados a partir de aislamientos”, expresó el biólogo Blas Dorta, con más de 40 años de experiencia y uno de los pioneros del proyecto.

Además, se desarrollan dos biocontroladores importantes, uno llamado Deltabac, creado con base en la bacteria entomopatógena Bacillus Thuringiensis en variedad Kurstaki como agente de biocontrol; y Metar, formulado con base en el hongo Metarhizium anisoplae, empleados para el control biológico de lepidópteros o polillas, en el caso de las palometas peludas.
“Con esta variedad desarrollamos un bioinsecticida para el control de la palometa peluda. Se hicieron todos los estudios para el escalamiento del producto y luego en la empresa asociada Agrobiotec, una empresa universitaria, se realizaron todos los desarrollos biotecnológicos. Allí, este biocontrolador se masificó y se utilizó a gran escala para el control de la plaga, y lo logramos. Fue un problema resuelto con base en el estudio bien disciplinado, multidisciplinario y preciso en donde nos planteamos, justamente buscar soluciones a problemas nacionales”, destacó Dorta.
Del mismo modo, precisó que la iniciativa nació como respuesta ante el problema de proliferación de las palometas peludas. “A finales de 2021 y principios de 2022, hubo una explosión poblacional muy grande de esta plaga, se llegaron a cuantificar, tanto en trampa de luz como en alumbrado público, alrededor de 260 millones de palometas volando. Después de eso, llegamos a la situación actual, en el último ciclo, donde en todo el estado Sucre se detectaron alrededor de 32 palometas y eso se deba a este insecticida desarrollado por nosotros”.
Adicionalmente, de este equipo de expertos, nació también el bioinsecticida formulado con base a la bacteria Bacillus Thuringiensis, pero con la variedad Tenebrionis, para el control de coleópteros, conocidos como coquitos o gorgojos, y otros insectos que afectan granos y harinas almacenadas.
Igualmente, elaboraron el biocontrolador denominado Larvibac, actualmente en fase de desarrollo, creado en base en la bacteria Bacillus sphaericus, usado para el control de los mosquitos: Aedes aegypti; Culex, y Anófeles, agentes transmisores de enfermedades como malaria, fiebre amarilla, dengue, chikungunya y zika.
En la actualidad, están enfocados en el desarrollo de un quinto biocontrolador, con base al hongo entomopatógeno llamado Nomuraea rileyi, para el control de plagas exfoliadoras en la agricultura, como el gusano cogollero del maíz, que pueden llegar a afectar más de 80 especies de plantas y causar daños a cereales cultivados de importancia económica, como el arroz, el sorgo, además de hortalizas y el algodón.
Hacer ciencia para el país
Las jóvenes científicas Brenda Salazar y Fabiola Pinto, de 27 y 28 años, respectivamente, han jugado un papel fundamental para el desarrollo de estos biocontroladores.
En el laboratorio del IBE realizan todo el proceso de producción de los bioproductos a partir de cepas de microorganismos que conservan bajo condiciones adecuadas y se multiplican en medios de cultivo especial.
“Nos aseguramos de tener los inóculos completamente puros y de darles a las bacterias todos los requerimientos nutricionales y de oxigenación que necesitan, no solo para crecer sino para generar subproductos que nos permitan atacar a las plantas”, así lo explica la bióloga Brenda Salazar.
La idea de desarrollar estos biocontroladores va ligada a impulsar un cambio de mentalidad, orientada a contribuir con la preservación de la vida en el planeta y la salvación de la especie humana registrado en el V Objetivo Histórico del Plan de la Patria.
“Aquí desarrollamos medios de cultivo de bajo costo, porque hay medios de cultivos definidos con reactivos de laboratorios que tienen alto costo, pero nosotras trasladamos ese medio y lo reformulamos con subproductos. En este caso utilizamos melaza de caña de azúcar, agua de maceración de maíz, como subproductos de la industria agrícola”.

Asimismo, Salazar resaltó que, en el proceso, “le damos todos los requerimientos necesarios para que la bacteria no solo crezca, sino que produzca sus esporas, todas son bacterias esporuladas, que, además, generan un cristal que es una estructura proteica, que se va a convertir en la toxina que afecta a los insectos blancos una vez que ellos los ingieren”.
Esta iniciativa contribuye a mejorar la calidad de vida, “es aportar un granito de arena, ya que con nuestro trabajo ofrecemos soluciones a problemas de salud pública, además de contribuir con el fortalecimiento de la producción agroalimentaria nacional”.
_Oficina de Gestión Comunicacional del Ministerio del Poder Popular para Ciencia y Tecnología/Periodista: Nailet Rojas Garcia/Fotógrafo: Francisco Trias
